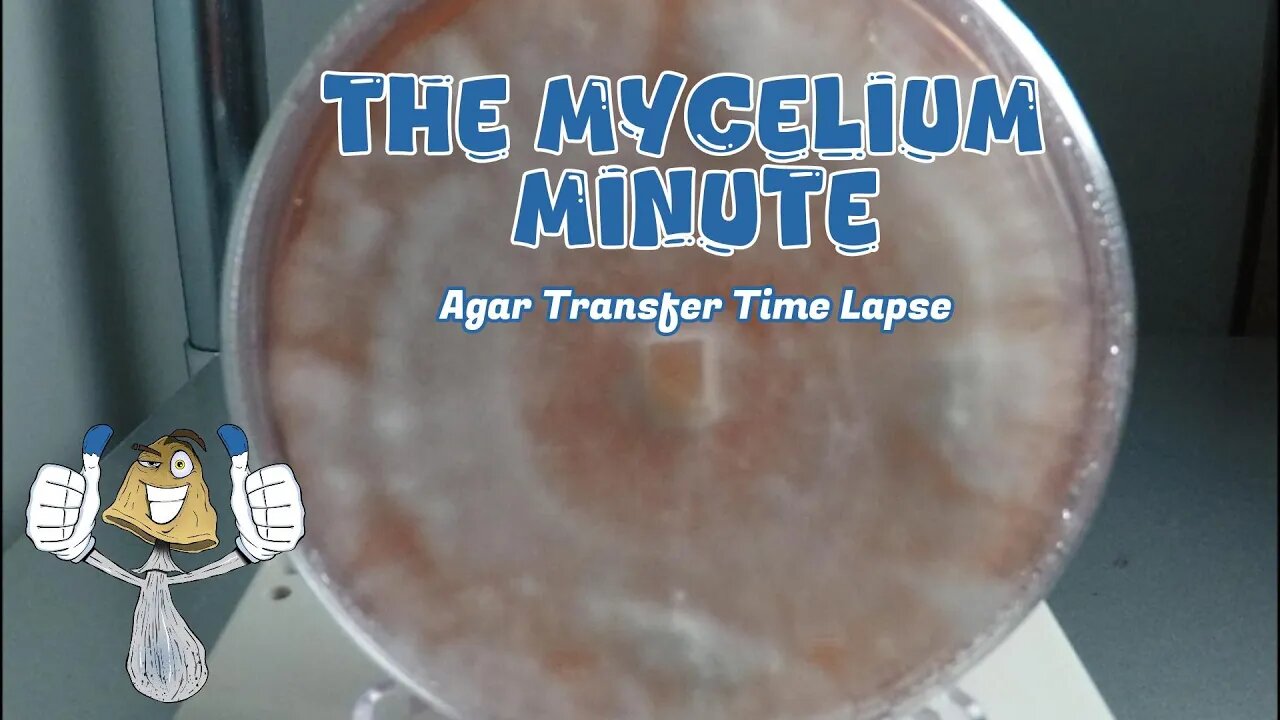

Premium Only Content
Agar Transfer Time Lapse | The Mycelium Minute
Welcome to my youtube channel EazyBlueThumb New Video!
📌 Agar Transfer Time Lapse | The Mycelium Minute | Eazy BlueThumb
This video, *Agar Transfer Time Lapse*, by EazyBlueThumb, is part of *The Mycelium Minute* series, focusing on the fascinating growth process of mycelium as it spreads across agar plates. The time-lapse format allows viewers to observe mycelium growth over a period of days or weeks compressed into a few minutes. Viewers can witness the mycelium’s delicate, branching pattern as it colonizes its new environment, making this both an educational and visually captivating experience for those interested in mycology. EazyBlueThumb guides the audience through each step, highlighting techniques and tips for successful agar transfers in the lab or at home, emphasizing the importance of sterile conditions. Perfect for beginners and experienced mycologists alike, the video illustrates the science and art behind mycelium cultivation.
Yo Shroomies! check out this dope time lapse footage of an agar transfer colonizing a petri dish! This footage was acquired over a 3-4 week period. I hope you all enjoy!
New Amazon Storefront
https://www.amazon.com/shop/eazybluethumb
Subscribe to my Patreon!
https://patreon.com/EazyBlueThumb
Join my Discord server!
https://discord.gg/SqSbsTy52m
Looking For Some Shroomie Gear?
https://eazybluethumb.com
Email: [email protected]
______________________________________________________________
.::. Amazon Supply List .::.
Elite Gourmet Programmable Food Dehydrator 6 Stainless Steel Trays
(NO NEED TO CUT YOUR MUSHROOMS!)
https://amzn.to/3NYlz38
Electric Herb Grinder Compact Size, Easy On/Off,
https://amzn.to/3XI2oxN
Coco Bliss Coco Coir - Compressed (650 Grams, 10 Bricks)
https://amzn.to/3NYULQv
Mushroom Growing Still Air Box-Pop up Mushroom Grow Tent
https://amzn.to/3D78777
4 Pack of Torch Lighter, Jet Flame, Butane Gas, Mini Refillable
https://amzn.to/3Jy6EtZ
Ultra Fine Plastic Water Mist Sprayer
https://amzn.to/3JyyPcp
64 Pieces Synthetic Filter Paper Stickers Filter Disc and 100 Pieces Rubber Stopper Injection Ports (13.2mm Diameter)
https://amzn.to/3r7oopy
Medical Tape Paper (micropore)- 1”x10 Yards Box of 12 Rolls
https://amzn.to/43XZF5S
Scalpel Sterile Blades with #3#4 Scalpel Knife Handle & Storage Box
https://amzn.to/3JtCWWP
AC Infinity 6.6” Stainless Steel Curved Pruning Shear
https://amzn.to/437kHgZ
AC Infinity SUNCORE S3, Waterproof Seedling Heat Mat 10" x 20.75"
https://amzn.to/3CKn4vD
AC Infinity SUNCORE T3, Seedling Mat with Digital Thermostat and Heat Controller 10” x 20.75”
https://amzn.to/3PxeYOp
AC Infinity Advance Grow System 2x2 WiFi
https://amzn.to/47UHPTp
1000ml Glass Round Media Storage Bottles
https://amzn.to/44yTggW
Ball Half Gallon Wide Mouth Canning Jars (6 Count)
https://amzn.to/3OZru7h
Agar Agar Powder, 1lb | Vegan
https://amzn.to/3EkSSbi
.::. Support The Channel .::.
All donations 100% Up To You!
I REPEAT 100% voluntarily.
I will NEVER contact you asking for money of any sort
on ANY PLATFORM!!
✅✨ Thank you for watching this video, Click the "SUBSCRIBE" button to stay connected with this channel. ✅✨
🎯Subscription Link: https://www.youtube.com/@UCHJbS2D1ik4H0KrBCwcaSHQ
💡You Might Also Like:
Brown Rice Saga Episode: 4 | Eazy BlueThumb- https://www.youtube.com/watch?v=nEN2V0DGAHM
Mycology Supplies 101 | Complete Beginners Guide | Eazy BlueThumb- https://www.youtube.com/watch?v=ADZfR_V_OKE
BenQ ideaCam S1 Webcam Review | EazyBlueThumb- https://youtu.be/5lMrT6dc24k?si=MaR5DNilfjMYMi15
New Pet Unboxing | What's In The Bag? EazyBlueThumb- https://youtu.be/aN7Jip2T7wo?si=YoVXmBlRrPgXdUVC
Baby Boa Constrictor | Live Feed | Eazy BlueThumb- https://www.youtube.com/watch?v=Dr1gSyXV5-Q
💟My playlist:
Everything with Scales- https://www.youtube.com/watch?v=Dr1gSyXV5-Q&list=PLtEA34Zcq51ZijMF6J8TI9qgP2VIz7KZn&pp=iAQB
The Brown Rice Saga- https://www.youtube.com/watch?v=QrRnGa85IHY&list=PLtEA34Zcq51bDpwM-Ob0d4jxf18RrRdDD&pp=iAQB
Uncle Ben's Tek- https://www.youtube.com/watch?v=S0Mfx3uCl04&list=PLtEA34Zcq51Zoo_sDG2TB2R7M76UyGwXR&pp=iAQB
✅ Don't forget to like, share, and subscribe to my YouTube channel. ✨
Keywords- Agar Transfer Time Lapse | The Mycelium Minute | Eazy BlueThumb, Agar Transfer Time Lapse | The Mycelium Minute EazyBlueThumb, EazyBlueThumb Agar Transfer Time Lapse The Mycelium Minute, EazyBlueThumb Agar Transfer Time Lapse, EazyBlueThumb, Agar Transfer Time Lapse The Mycelium Minute EazyBlueThumb, EazyBlueThumb The Mycelium Minute, Review, Product, Product Review, Agar Transfer Time Lapse The Mycelium Minute, Eazy BlueThumb, Agar Transfer Time Lapse EazyBlueThumb, The Mycelium Minute, The Mycelium Minute EazyBlueThumb.
Hashtag- #REVIEWS #PRODUCTREVIEW #UNBOXINGVIDEO #product #mycology #mycology101 #mycologyforbeginners #mycologylecture #completebeginnersguide #beginnersguide #eazybluethumb #productreviews #productreviewvideos #productreviewchannel
-
 LIVE
LIVE
Plan ₿ Forum
2 days agoWAGMI Stage – Lugano Plan ₿ Forum 2025 | Live from Lugano 🇨🇭
14,643 watching -
 LIVE
LIVE
The Rubin Report
21 minutes agoCrowd Roars for Cuomo’s Blistering Attack on Zohran Mamdani
633 watching -
 LIVE
LIVE
Stephan Livera
2 days agoDAY 1 - Stephan Livera hosts Plan B Podcast in Lugano
287 watching -
 LIVE
LIVE
LFA TV
13 hours agoLIVE & BREAKING NEWS! | FRIDAY 10/24/25
2,360 watching -
 12:29
12:29
Clintonjaws
14 hours ago $16.35 earnedShane Gillis vs 'The View' - This Is Priceless!
25.4K10 -
 LIVE
LIVE
Caleb Hammer
1 hour agoFinancial Audit's First Furry
48 watching -
 LIVE
LIVE
The Big Mig™
1 hour agoOperation Arctic Frost FAFO!
42 watching -
 DVR
DVR
VINCE
2 hours agoThe Dems Are Desperate So They're Breaking The Law | Episode 154 - 10/24/25
54.5K62 -
 LIVE
LIVE
Badlands Media
8 hours agoBadlands Daily: October 24, 2025
3,601 watching -
 LIVE
LIVE
Major League Fishing
8 days agoLIVE! - Fishing Clash Team Series: Patriot Cup - Day 3
145 watching